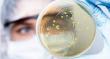

Old National Celebrates First Better Together Volunteer Event
CHICAGO, Oct. 03, 2022 (GLOBE NEWSWIRE) -- Old National Bank celebrated its first Better Together Volunteer Days on September 28th and 29th. The two-day event provided team members across Old National’s seven-state footprint the opportunity to volunteer …